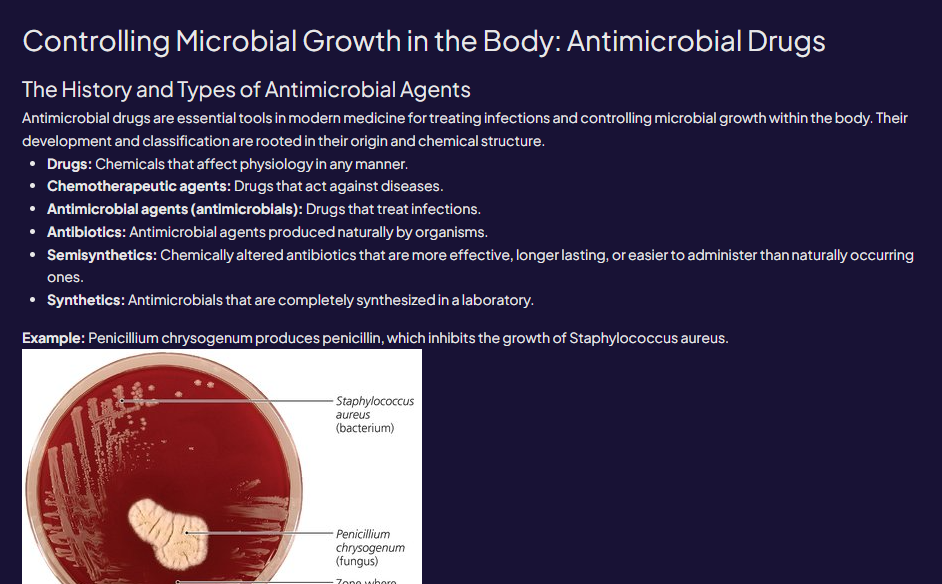
A petri dish showing Penicillium chrysogenum inhibiting the growth of Staphylococcus aureus

Back
BackControlling Microbial Growth in the Body: Antimicrobial Drugs
Study Guide - Smart Notes

Antimicrobial Drugs: History and Types
Introduction to Antimicrobial Agents
Antimicrobial drugs are vital in modern medicine for treating infections and controlling the growth of microbes within the human body. Their classification is based on their origin and chemical structure, which determines their effectiveness and application in clinical settings.
Drugs: Chemicals that affect physiology in any manner, not limited to infection control.
Chemotherapeutic agents: Drugs specifically designed to act against diseases, including infections and cancers.
Antimicrobial agents (antimicrobials): Drugs that treat infections by inhibiting or killing microorganisms such as bacteria, fungi, viruses, or protozoa.
Antibiotics: A subset of antimicrobials produced naturally by living organisms (often fungi or bacteria) that inhibit or destroy other microbes.
Semisynthetics: Antibiotics that have been chemically modified to enhance their effectiveness, duration of action, or ease of administration compared to their natural counterparts.
Synthetics: Antimicrobial agents that are entirely synthesized in the laboratory, with no direct natural origin.
Example: Penicillium chrysogenum produces penicillin, a natural antibiotic that inhibits the growth of Staphylococcus aureus, a common pathogenic bacterium.
Additional info: The discovery of penicillin by Alexander Fleming in 1928 marked the beginning of the antibiotic era, revolutionizing the treatment of bacterial infections and significantly reducing mortality from infectious diseases.
